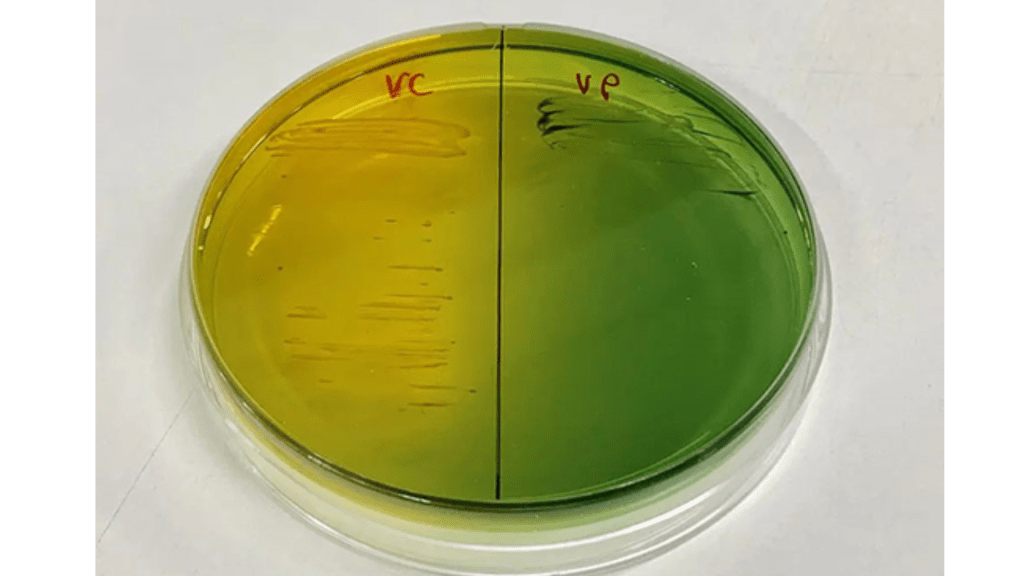

Thông tin dịch bệnh
Thủy sản

Làm sao để An toàn sinh học trong tầm tay người nuôi tôm? (Phần 1)
An toàn sinh học là lá chắn quan trọng giúp ngăn ngừa nguy cơ mất mùa, bảo toàn vốn và tiết kiệm chi phí. An toàn sinh học không phải chỉ trên lý thuyết, xa vời thực tế. Một số công việc người nuôi đang thực hiện hàng ngày thực chất là một phần của chiến lược an toàn sinh học mà họ ít/không để ý.

Làm sao để An toàn sinh học trong tầm tay người nuôi tôm? (Phần 2)
Ở phần 2 này, chúng tôi sẽ chi tiết hơn những gì người nuôi tôm thành công thường làm để bảo đảm An toàn sinh học trong các hoạt động hàng ngày.

Làm sao để An toàn sinh học trong tầm tay người nuôi tôm? (Phần 3)
Giảm thiểu số lượng mầm bệnh bằng cách nào?

Các biểu hiện của tôm khi bị nhiễm ký sinh trùng.
Khi tôm bị nhiễm ký sinh trùng, chúng thường biểu hiện qua nhiều dấu hiệu khác nhau liên quan đến hành vi, hình thái và sức khỏe tổng thể.

Cần làm gì để phòng ngừa TPD thời điểm này.
Bệnh hậu ấu trùng trong suốt, tôm gương hay tôm thủy tinh (TPD) bùng phát mạnh mẽ trở lại từ đầu năm nay ở quy mô rộng trên cả nước, ảnh hưởng không chỉ ở giai đoạn đầu 1-7 ngày sau khi thả giống mà còn xuất hiện và gây thiệt hại nhiều ở giai đoạn tôm hơn 20 ngày tuổi, thậm chí sau khi đã sang ao.

Vibrio gây bệnh TPD có những đặc điểm gì?
Từ khi bệnh TPD xuất hiện, những nhà khoa học Trung Quốc đã tiến hành nghiên cứu xác định được tác nhân và cơ chế gây bệnh. Bài viết này MSD mong muốn tổng hợp thông tin cập nhật về bệnh TPD để người nuôi có những cách tiếp cận phù hợp, từ đó có những giải pháp ngăn ngừa hiệu quả
Vibrio – Đánh giá độc lực qua màu sắc khuẩn lạc được không?
Màu sắc khuẩn lạc Vibrio phụ thuộc vào khả năng phân giải đường succrose trên môi trường đĩa thạch TCBS. Độc lực của Vibrio phụ thuộc vào khả năng tương tác giữa Vibrio với vật chủ và vi sinh khác trong môi trường.

Khóa Quorum sensing – Phương pháp thay thế kháng sinh trong tương lai
Quorum sensing (QS) là quá trình giao tiếp của các tế bào vi khuẩn bằng cách truyền các phân tử, gen mã hóa cho nhau. Khi vi khuẩn tiếp nhận các giao tiếp này sẽ sinh trưởng tạo quần thể, tạo màng sinh học (biofilm), thực hiện trao đổi chất, gây độc tính và đáp ứng các điều kiện sống căng thẳng (stress).

Các giải pháp kiểm soát vi bào tử trùng EHP
Để lây nhiễm được vào cơ quan gan tụy tôm, EHP phải được “nảy mầm”- quá trình phóng vòi móc, giúp EHP gắn vào thụ thể trên bề mặt tế bào gan tụy, đường ruột tôm, khởi động quá trình truyền vật chất di truyền và nhân lên bên trong tế bào vật chủ

Kinh nghiệm phòng ngừa dịch bệnh đỏ thân đốm trắng
Bệnh do vi rút đốm trắng gây trên tôm với tỷ lệ chết rất cao và khả năng lây nhiễm nhanh, dẫn tới thiệt hại kinh tế lớn. Bệnh thường xuất hiện vào mùa lạnh khi chuyển thời tiết và nhiệt độ xuống thấp.

Sớm biết điều này, giúp hạn chế tôm bị bệnh đường ruột
Bệnh đường ruột xảy ra ở mọi giai đoạn nuôi, từ lúc tôm mới thả việc bảo vệ gan tụy là quan trọng nhất, khi tôm lớn dần áp lực bệnh càng tăng lên đường ruột. Bệnh nhẹ thì phân nát, đứt khúc, tôm giảm ăn chậm lớn, nặng hơn thì gặp phân lỏng, ruột trống, phân trắng dẫn đến tôm óp thân, tăng size ngược và không ngừng hao hụt.
